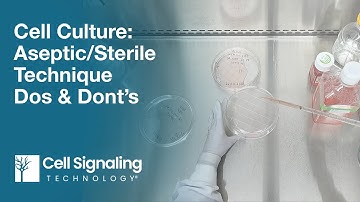
Cell Culture: Aseptic/Sterile Technique Dos & Don’ts | CST Tech Tips

⬇ DOWNLOAD NOW
Kalau muncul iklan pop-up, tutup lalu klik tombol kembali
Download lagu Cell Culture Best Practices: Getting Started (updated) secara gratis hanya untuk keperluan promosi. Dukung artis favorit kamu dengan membeli musik original di iTunes atau platform resmi lainnya.
 Cell Culture Video: Step-by-Step Guide to Passaging Cells
Cell Culture Video: Step-by-Step Guide to Passaging Cells
 Getting Started with Tissue Culture
Getting Started with Tissue Culture
 1) Cell Culture Tutorial - An Introduction
1) Cell Culture Tutorial - An Introduction
 HEK 293 Cell Handling Best Practices Video
HEK 293 Cell Handling Best Practices Video
 Cell Culture Best Practices
Cell Culture Best Practices
 Mastering Cell Culture Lab: 5 Essential Good lab Practices (GPL) for Biotech| Cell Culture Tips
Mastering Cell Culture Lab: 5 Essential Good lab Practices (GPL) for Biotech| Cell Culture Tips
 Best Practices in Cell Culture (1)
Best Practices in Cell Culture (1)
Cell Culture: Aseptic/Sterile Technique Dos & Don’ts | CST Tech Tips
Cell Culture: Aseptic/Sterile Technique Dos & Don’ts | CST Tech Tips